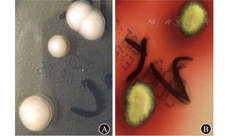

艾滋病(acquired immunodeficiency syndrome,AIDS)主要侵犯人体免疫系统,最终导致人体免疫功能缺陷,引起各种机会性感染和肿瘤发生。噬血细胞综合征(hemophagocytic syndrome,HPS)是一类由原发性或继发性免疫异常导致的过度炎症反应综合征,具有病情进展快、致死率较高的特点。现报道1例AIDS并发HPS,同时伴发马尔尼菲篮状菌(talaromyces marneffei,TM)病、淋巴瘤的患者,以及其诊疗经过,为临床治疗提供参考。

版权归中华医学会所有。
未经授权,不得转载、摘编本刊文章,不得使用本刊的版式设计。
除非特别声明,本刊刊出的所有文章不代表中华医学会和本刊编委会的观点。
患者男,28岁,因"发热、咳嗽10 d余,HIV抗体初筛阳性5 d"于2018年5月8日入院。患者入院前10 d余开始发热,峰值达40.0 ℃,间歇发热,伴有咳嗽;至当地医院就诊查胸部X线片,提示肺炎;实验室检查示:CRP值为55.4 mg/L,ESR值为104.0 mm/1 h,ALT水平为100.0 U/L,AST水平为112.0 U/L,白蛋白值为30.3 g/L,遂予降温、抗细菌感染、抗病毒感染、止咳祛痰等对症支持治疗(具体不详);治疗后咳嗽好转,仍发热,后因HIV抗体检测呈阳性,转至南通市第三人民医院传染科就诊。入院体格检查:体温为36.5 ℃,心率为76次/min,呼吸频率为16次/min,血压为102/64 mmHg(1 mmHg=0.133 kPa);患者神志清,精神一般;头面、躯干、四肢有散在暗红色斑疹、丘疹,部分丘疹呈脐窝状,未触及明显肿大淋巴结;口腔黏膜见白斑;胸部、腹部体格检查未见明显异常;患者双侧病理征呈阴性。入院诊断:艾滋病、肺部感染、口腔念珠菌感染、肝功能损伤、低白蛋白血症。入院后予哌拉西林钠他唑巴坦钠(4.5 g/次,1次/8 h)联合莫西沙星(0.4 g/次,1次/d)静脉滴注抗细菌感染,复方磺胺甲口恶唑(4.32 g/次,3次/d)口服抗肺孢子菌感染,制霉菌素片(100万单位/次,3次/d)口服抗口腔念珠菌感染,氟康唑(0.4 g/次,1次/d)静脉滴注抗真菌感染,复方甘草酸苷(80.0 mg/次,1次/d)静脉滴注保护肝功能,人血白蛋白(10.0 g/次,1次/d)静脉滴注维持营养等治疗。入院2 h后患者体温升至39.7 ℃,实验室检查示:白细胞计数为1.16×109/L,中性粒细胞比例为0.94,中性粒细胞计数为1.09×109/L;PT为13.30 s,纤维蛋白原水平为3.58 g/L,D-二聚体为29.10 mg/L。遂予低分子肝素钙(4 100.0 IU/次,1次/12 h)皮下注射抗凝,重组人粒细胞刺激因子(150.0 μg/次,1次/d)皮下注射以升高白细胞水平。患者病程期间仍持续高热,峰值为39.5 ℃。实验室检查示:白细胞计数为0.70×109/L,血红蛋白值为92.00 g/L,血小板计数为87.00×109/L,中性粒细胞计数为0.55×109/L;PT值为14.00 s,INR值为1.20,纤维蛋白原水平为2.66 g/L,D-二聚体为56.91 mg/L;CRP值为151.00 mg/L;ESR值为25.00 mm/1 h;血清真菌特异性细胞壁成分(1,3)-β-D-葡聚糖检测结果为0.17 ng/L;梅毒螺旋体抗体检测呈阳性,非螺旋梅毒抗原试验比值为1∶8,结果呈阳性;HIV RNA定量为5.72×105 IU/mL;CD4 +T淋巴细胞计数为1/μL,CD8+T淋巴细胞计数为12/μL,自然杀伤细胞计数为3/μL;CMV DNA定量为1.41×103拷贝/mL;EB病毒DNA定量为3.48×105拷贝/mL;痰涂片未找到真菌、霉菌孢子;痰涂片未找到抗酸杆菌;痰涂片未找到革兰阴性杆菌,找到革兰阳性球菌;痰培养呈阴性;曲霉菌半乳甘聚糖抗原检测呈阴性;T-SPOT.TB检测呈阴性。心电图检查示:窦性心动过速。全腹部CT检查示:胆囊占位,腹腔及腹膜后多发轻度肿大淋巴结,考虑淋巴瘤;肝脏多发血管瘤;脾脏肿大;盆腔积液;右侧胸腔及心包少量积液。胸部CT检查示:两肺多发小结节,右侧颈根部、纵隔及两肺门多发肿大淋巴结,提示淋巴瘤;两肺炎症;心包少量积液,心包囊肿;腹腔及腹膜后轻度肿大淋巴结。入院第3天改哌拉西林钠他唑巴坦钠为亚胺培南西司他丁钠(1.0 g/次,1次/ 8 h)静脉滴注抗感染治疗,改氟康唑为伏立康唑)(用药第1天,伏立康唑剂量为400.0 mg/次,1次/12 h,之后为200.0 mg/次,1次/12 h)口服抗真菌治疗,并加用更昔洛韦(0.25 g/次,1次/ 12 h)联合膦甲酸钠(3.0 g/次,1次/12 h)静脉滴注抗病毒治疗,重组人粒细胞刺激因子(150 μg/次,2次/d)皮下注射升高白细胞计数。入院第4天患者体温下降,峰值为37.8 ℃。复查实验室检查示:白细胞计数为0.85×109/L,血红蛋白值为94.00 g/L,血小板计数为45.00×109/L,中性粒细胞计数为0.71×109/L;PT值为13.80 s,纤维蛋白原水平为1.42 g/L,D-二聚体水平为83.38 mg/L;血清铁蛋白值>2.00 μg/L;网织红细胞百分比为0.43%。考虑噬血细胞综合征(hemophagocytic syndrome,HPS)可能,予免疫球蛋白(20.0 g/次,1次/d)联合甲泼尼龙琥珀酸钠(40.0 mg/次,1次/8 h)静脉滴注冲击治疗7 d,入院第5天患者体温恢复正常。病程中行骨髓穿刺术、骨髓涂片检查。瑞氏-吉姆萨染色结果(图1A)示:有核细胞增生尚活跃,粒系、红系细胞计数比为0.85∶1;粒细胞增生减低,胞体偏大;红系细胞增生活跃,未见明显异常;全片见巨核细胞19个,血小板成簇可见;组织细胞占17.5%,可见双核细胞,易见吞噬性组织细胞;可见疑似被细胞吞噬的成簇菌体或原虫。过碘酸希夫反应染色检查结果(图1B)示:吞噬性组织细胞增多;考虑马尔尼菲篮状菌(talaromyces marneffei,TM)感染可能,原虫感染不排除,建议骨髓培养。血培养检查提示TM感染(图2)。根据患者症状、体征和上述检查结果,考虑患者"HPS、TM感染"诊断明确;遂停用伏立康唑,改为两性霉素B(25.0 mg/次,1次/d)静脉滴注抗真菌治疗。病情缓解后甲泼尼龙琥珀酸钠逐渐减量,予苄星青霉素(240.0万单位/次,每周1次)肌内注射抗梅毒感染治疗(连用3周)。在南通市CDC确诊该患者HIV-1抗体呈阳性后,遂予HAART至今,即口服拉米夫定(300.0 mg/次,1次/d)、替诺福韦(300.0 mg/次,1次/d)、依非韦伦(600.0 mg/次,每晚1次);两性霉素B使用2周后停用,改为伊曲康唑(20.0 mL/次,2次/d)口服抗真菌治疗。复查血常规、生物化学指标、凝血功能指标、CMV DNA定量、血培养指标,行骨髓涂片检查、骨髓培养检查,均未见异常;胸部CT检查示肺部炎症明显吸收;腹部CT检查提示胆囊占位进展,腹腔及腹膜后多发肿大淋巴结,考虑淋巴瘤可能;请外科会诊后建议行腹腔镜胆囊切除术,并且术中行活组织病理检查了解淋巴瘤分型和分级,患者拒绝行手术并要求出院,出院后予嘱继续口服伊曲康唑治疗。




患者出院11 d后再入院行腹腔镜胆囊切除术,术后病理(胆囊)示:高级别B细胞淋巴瘤,结合免疫表型,考虑弥漫大B细胞淋巴瘤,予CHOP方案化学治疗[环磷酰胺(cyclophosphamie)、表柔比星(epirubicin)、长春新碱(vincristine)、泼尼松(prednisone)];间隔21 d开始下一个化学治疗疗程。第5个疗程前复查腹部CT检查,提示腹腔内及腹膜后多发小至轻度肿大淋巴结,与化学治疗前相比,部分缩小,部分大小相仿,双侧腹股沟区淋巴结较前缩小。但患者未遵循医嘱,未继续执行第6次化学治疗。
依据2009年美国血液病学年会制订的诊断标准[1],本例患者急性起病,高热,肝脏损伤,外周循环红系、粒系、血小板三系细胞减少,脾脏肿大,血清铁蛋白水平明显升高,纤维蛋白水平降低,同时骨髓涂片易见吞噬性组织细胞,HPS诊断明确。HPS分为原发性和继发性,其中原发性HPS主要与遗传性基因突变相关,新生儿、儿童多发,预后不良;继发性HPS多发生于成年人,主要病因有感染、肿瘤、自身免疫病等[2]。本例患者系HIV感染,查CD4+T淋巴细胞计数仅为1/μL,其免疫功能低下;同时,骨髓涂片检查提示TM感染可能,该菌的感染协同HIV可参与HPS的发生[3],但是患者第1次骨髓穿刺样本未行骨髓培养,因此尚不能完全明确TM病诊断。HPS病情进展快,在疾病早期应尽快行骨髓检查以明确诊断,尽早治疗以促进患者恢复。
TM病是由TM引起的一种深部真菌感染,多发生在艾滋病和其他免疫抑制患者中,诊断依据主要为病原学检测和活组织病理学检查。本例患者血培养提示TM感染。根据《中国艾滋病诊疗指南(2018版)》[4],以及考虑患者经济情况,选用两性霉素B联合伊曲康唑口服液治疗,可起到一定的临床效果。TM治疗的关键在于早期诊断,本例患者具有特征性皮疹,结合其流行病学特点,考虑TM感染。但患者的中央坏死性脐状丘疹并非TM病特异性皮疹。有研究表明,艾滋病伴TM感染出现特征性皮疹的发生率<50%[5,6]。因TM患者临床表现缺乏特异性,且血培养、骨髓培养周期长,故骨髓涂片结果可作为重要参考,有助于早诊断、早治疗。
艾滋病相关淋巴瘤以非霍奇金淋巴瘤为主,其最常见的亚型是伯基特淋巴瘤和弥漫大B细胞淋巴瘤(diffuse large B-cell lymphoma,DLBCL)[7]。本例患者系艾滋病明确诊断合并DLBCL,同时检查EB病毒DNA定量呈阳性。EB病毒感染已被证实与多种恶性肿瘤发生相关,如淋巴瘤、鼻咽癌、胃癌等[8];但EB病毒是否参与该例患者淋巴瘤的发生、发展,尚不明确,因未检测该例患者胆囊病理组织中EB病毒的表达水平;而且未进一步检测其外周血、EB病毒激活后的蛋白质表达情况,如EB病毒膜蛋白、EB病毒核抗原和非翻译的EB病毒RNA。研究显示,艾滋病患者需尽早启动HAART,有助于降低机会性感染和恶性肿瘤的发生概率。报道显示,R-CHOP [利妥昔单克隆抗体(rituximab)合并环磷酰胺、表柔比星、长春新碱、泼尼松]方案联合HAART,能够提高艾滋病相关淋巴瘤(acquired immunodeficiency syndrome related lymphoma,ARL)缓解率,以及患者的生存率[9]。本例患者采用CHOP方案化学治疗5次,化学治疗后复查腹部CT检查提示部分淋巴结肿大程度较前相仿且部分淋巴结缩小,病情有所缓解;但因个人原因未能完成化学治疗,将继续随访跟踪患者病情发展及转归。
所有作者均声明不存在利益冲突